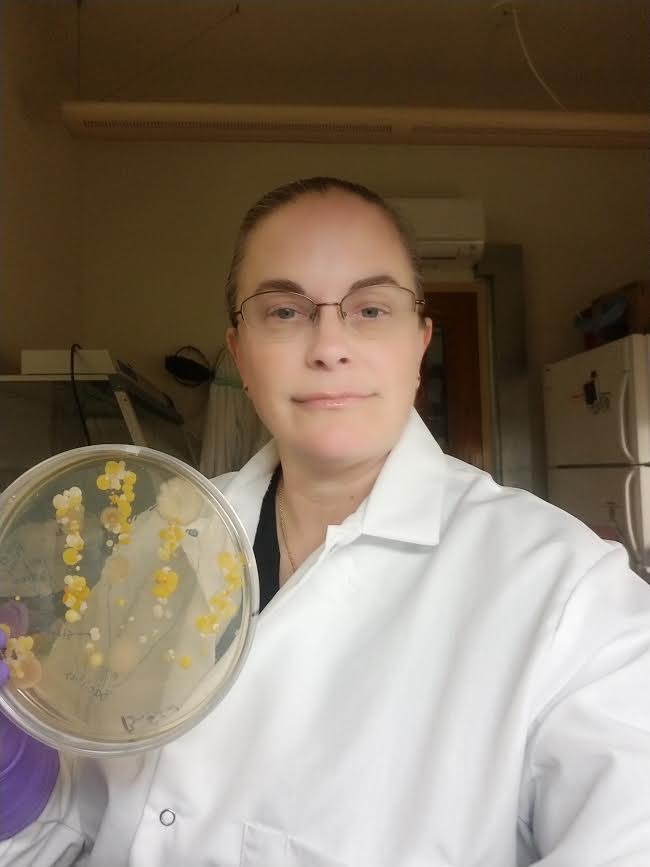

Tasha Sturm
I graduated with a BS in biology and a minor in Immunology from Cal State Fullerton. For the last 17 years I have been a lab coordinator at Cabrillo College, where I set up labs for the Microbiology, Physiology, and Anatomy courses. My true love is Microbiology and over the years I have done hundreds of environmental demonstration plates (handprints, show swabs, etc) for classes. In that time I have come to love the variety of textures and colors in the microbial world and even find joy in the occasional contaminated plate…..usually fungal. Photography is a way to share Microbiology both artistically and educationally.